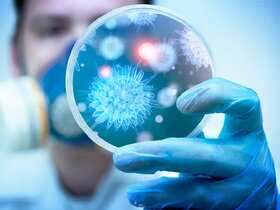

Все новости с тегом: Мухарская Людмила
15:18
Загрузка...
Білий дім звинуватив демократів у шатдауні, представивши їх у вигляді привидів на відео до Геловіну
 3
3
Співака-путініста Лепса терміново госпіталізували з важким отруєнням після концерту у Владивостоці
 3
3
Наши опросы
Верите ли вы, что Дональд Трамп сможет остановить войну между Россией и Украиной?
Показать результаты опроса
Показать все опросы на сайте
Показать результаты опроса
Показать все опросы на сайте